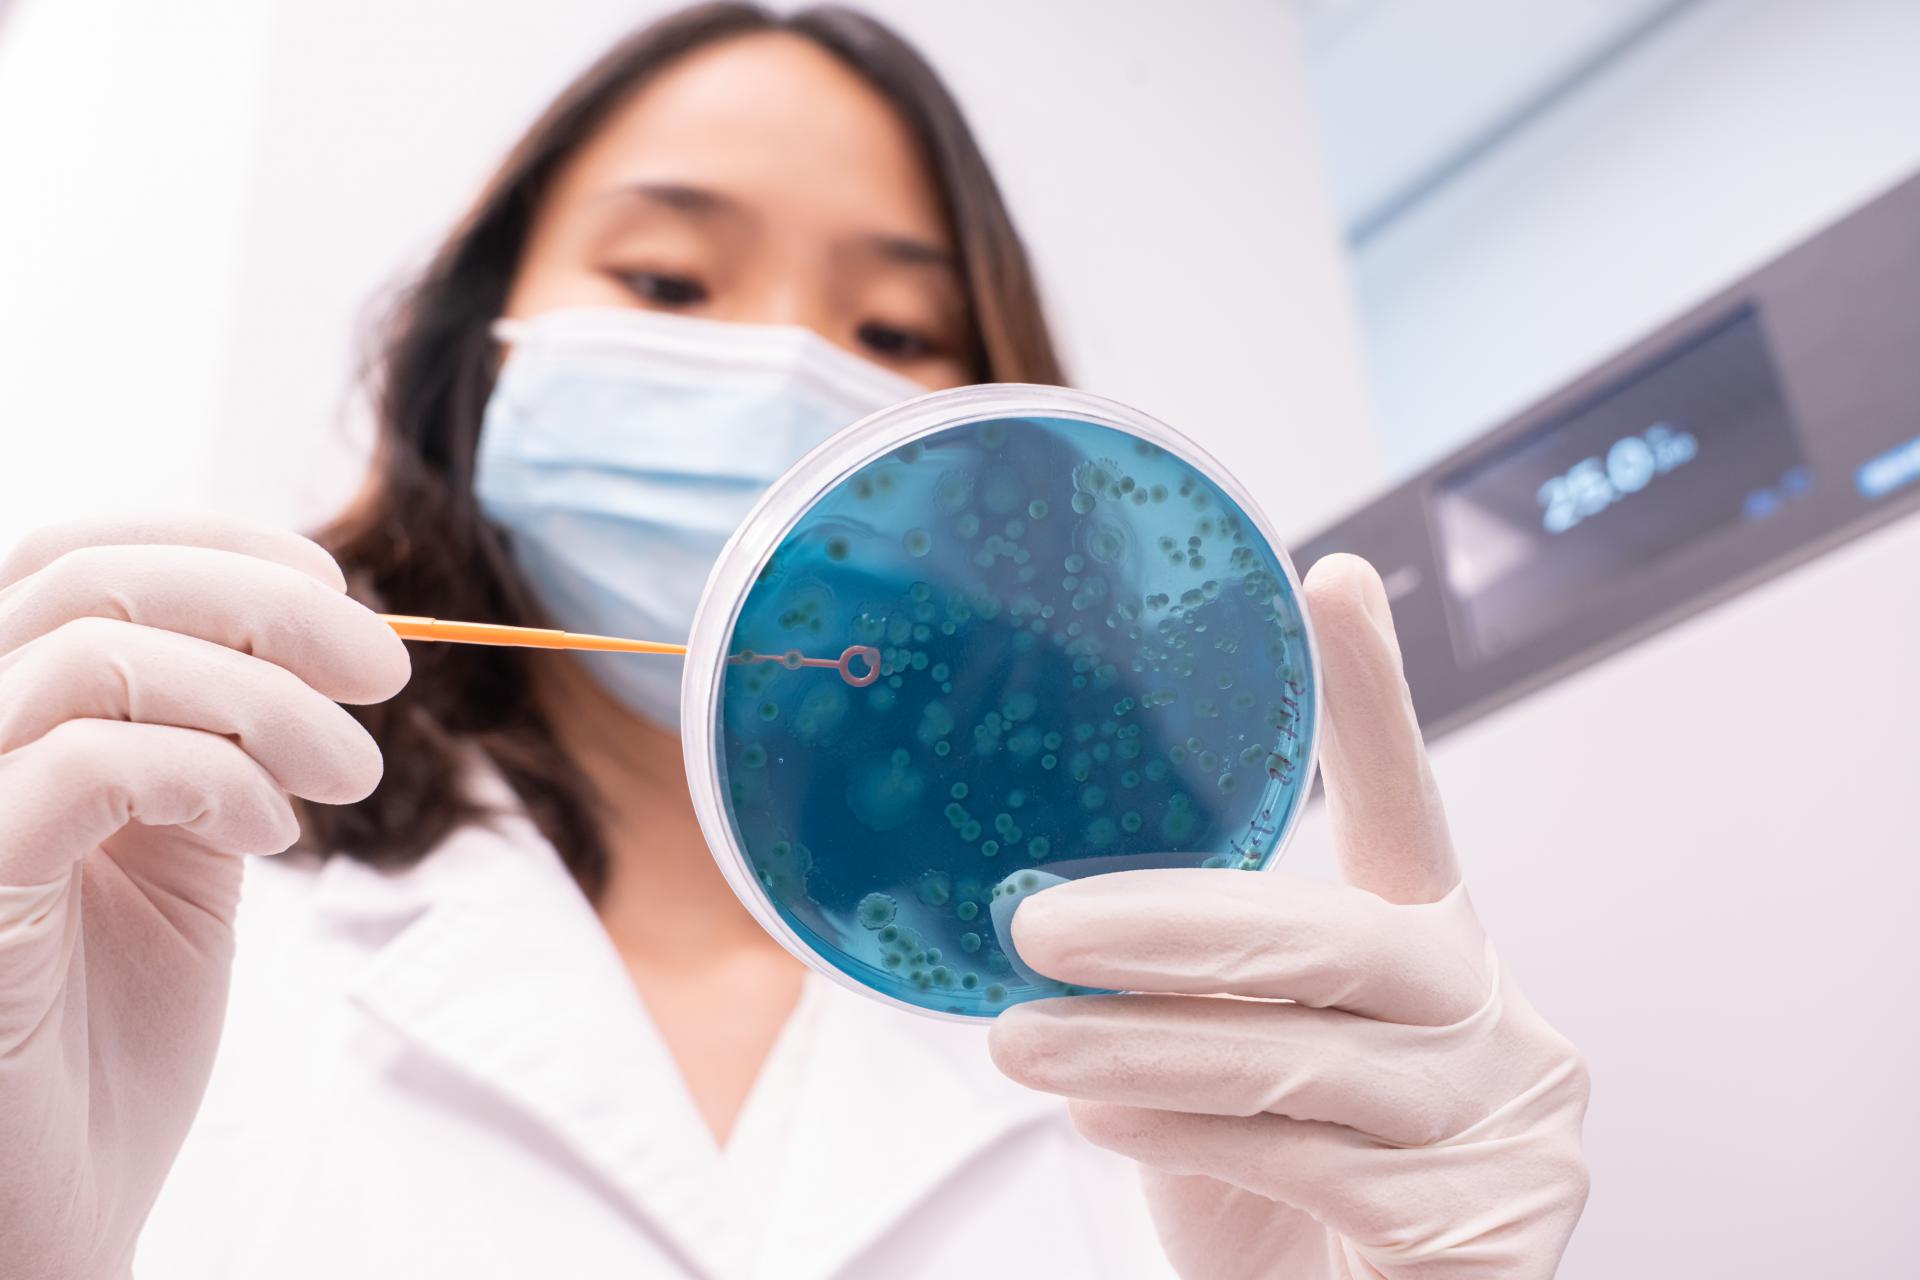

Directors: Prof Siew NG and Prof Francis CHAN
Company
Just as Magic is science yet to be discovered, the Microbiota I-Center (MagIC) harnesses and translates the human microbiome into cutting-edge innovations for early disease detection and prevention.
MagIC focuses on advancing science in the gut microbiome and promoting entrepreneurship. It is committed to developing a novel class of microbiome diagnostics and live biotherapeutics for common diseases including obesity, cancer, autism, inflammatory disorders and COVID-19, that will not only transform lives of patients and their families, but also accelerate Hong Kong into a world-class microbiome biotechnology hub.

Media
Many Diseases are related to Imbalance of Gut Microbiota (Dysbiosis), including Obesity, Irritable Bowel Syndrome, Inflammatory Bowel Disease, C. Difficile Colitis (CDI), and Graft-Versus-Host Disease. With Fecal Microbiota Transplantation (FMT), we can restore the balance of gut microbiota. The cure rate of treating patients with severe Clostridium difficile (C. difficile) infection is over 85% when using FMT, which is significantly higher than that of conventional antibiotic treatment.
Key research area
-
1
Healthy Microbiome in Early Life
-
2
Microbiome in Obesity and Metabolic Disease
-
3
Microbiome in Inflammatory Bowel Disease
-
4
Intestinal Microbiota Transplantation & Development of Microbial Products